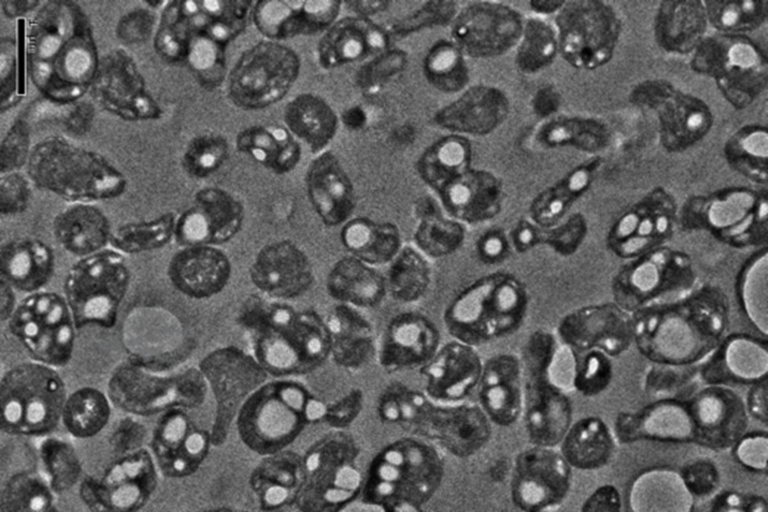
Microbial Processes

Complicated Science, Simple Solutions
We are leading the bio-industrial revolution by converting abundant methane gas into biodegradable materials.
A completely sustainable closed loop
Mango Materials’ core fermentation technology involves the production of a naturally occurring biopolymer from waste biogas (methane). This is how our process works:

From nature, back to nature
Methane Gas Emissions

An abundant source
We believe methane is a valuable resource. It is found all around the world and is the byproduct of many essential operations.

Waste to resource
Methane is a potent greenhouse gas. There are not many economically beneficial uses for this waste gas.

Coexist and capture
We co-locate our factories next to existing methane production facilities.

All types of methane
We can partner with all types of customers - landfills, wastewater treatment plants, agricultural facilities, etc.
Microbial Processes

Ancient bacteria
We utilize methanotrophs, some of the most ancient living organisms on the planet.

Natural process
Our bacteria produce PHA naturally. Similarily to how humans produce "fat", PHA is the bacteria's ancient carbon storage mechanism.

Selective criteria
Our methanotrophs are not currently genetically modified. Our process is developed using natural selection to allow the bacteria to produce PHA.

Robust mechanism
Our consortia of bacteria are not prone to invaders. They do not require pricey sterilization.
Creation of PHA Biopolymer

Carbon Storage Mechanism
Our methanotrophs store carbon inside of their cell walls in the form of PHA.

High Quality PHA
Our methanotrophs produce pure P3HB, one of the members of the PHA family.

Base Raw Material
P3HB is an excellent base polymer for YOPP and YOPP+, allowing tailoring of formulation for many applications.

Efficient & Scalable
The use of methane as a feedstock facilitates a low-cost, highly scalable process.
Biodegradable Products

Supply Chain Integration
We deliver formulated YOPP pellets that are incorporated into conventional plastics supply chains.

Compounding Expertise
Our YOPP and YOPP+ pellets are optimally-formulated for fibers (for apparel and textiles) and rigid goods (for jars, caps, and molded applications).

Tailoring for Biodegradability
Our formulated YOPP and YOPP+ pellets are custom-made for versatile end-of-life options, including marine biodegradability.

Brand Collaborations
We work directly with brand owners for their specific applications.
Waste Facility

Closed Loop
If YOPP or YOPP+ enters a modern waste facility (landfill, wastewater treatment plant) where methane is produced, it can be recaptured to make more PHA.

Natural Carbon Cycle
If YOPP or YOPP+ is accidently disposed of in the natural environment it becomes part of the naturally occurring carbon cycle. It does not persist and pollute.

No Dead-End Carbon
YOPP and YOPP+ have been designed to be completely consumed by microorganisms. The breakdown does not accumulate oligomers and leaves no trace of microplastics or microfibers.

Biodegradation Profile
YOPP fibers have been shown to biodegrade in ~6 weeks in the marine environment. Respirometric and weight loss studies have also been conducted.